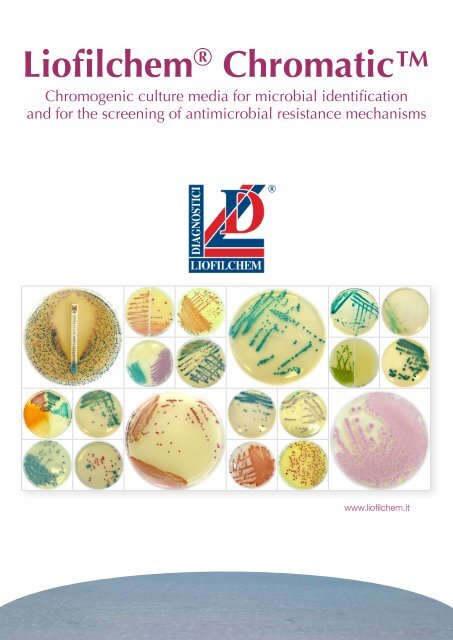

liofilchem is a globally recognized leader in the development and manufacturing of microbiological diagnostic products.Trusted by laboratories in over 130 countries from clinical diagnostics to industrial and food safety applications
BRANDS








liofilchem is a globally recognized leader in the development and manufacturing of microbiological diagnostic products.Trusted by laboratories in over 130 countries from clinical diagnostics to industrial and food safety applications